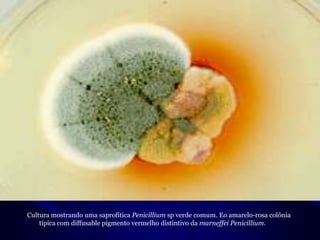
Cultura mostrando uma saprofítica Penicilliumsp verde comum. Eo amarelo-rosa colônia típica com diffusable pigmento vermelho distintivo da marneffeiPenicillium.
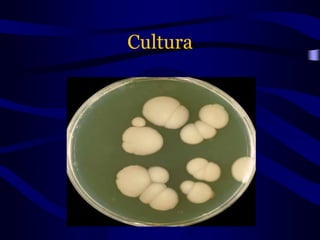

O documento discute micoses oportunistas causadas por fungos de baixa virulência que infectam pessoas imunocomprometidas, incluindo criptococose, peniciliose, candidíase, zigomicose e aspergilose. É fornecido detalhes sobre os agentes causadores, transmissão, sintomas e tratamento dessas infecções fúngicas.